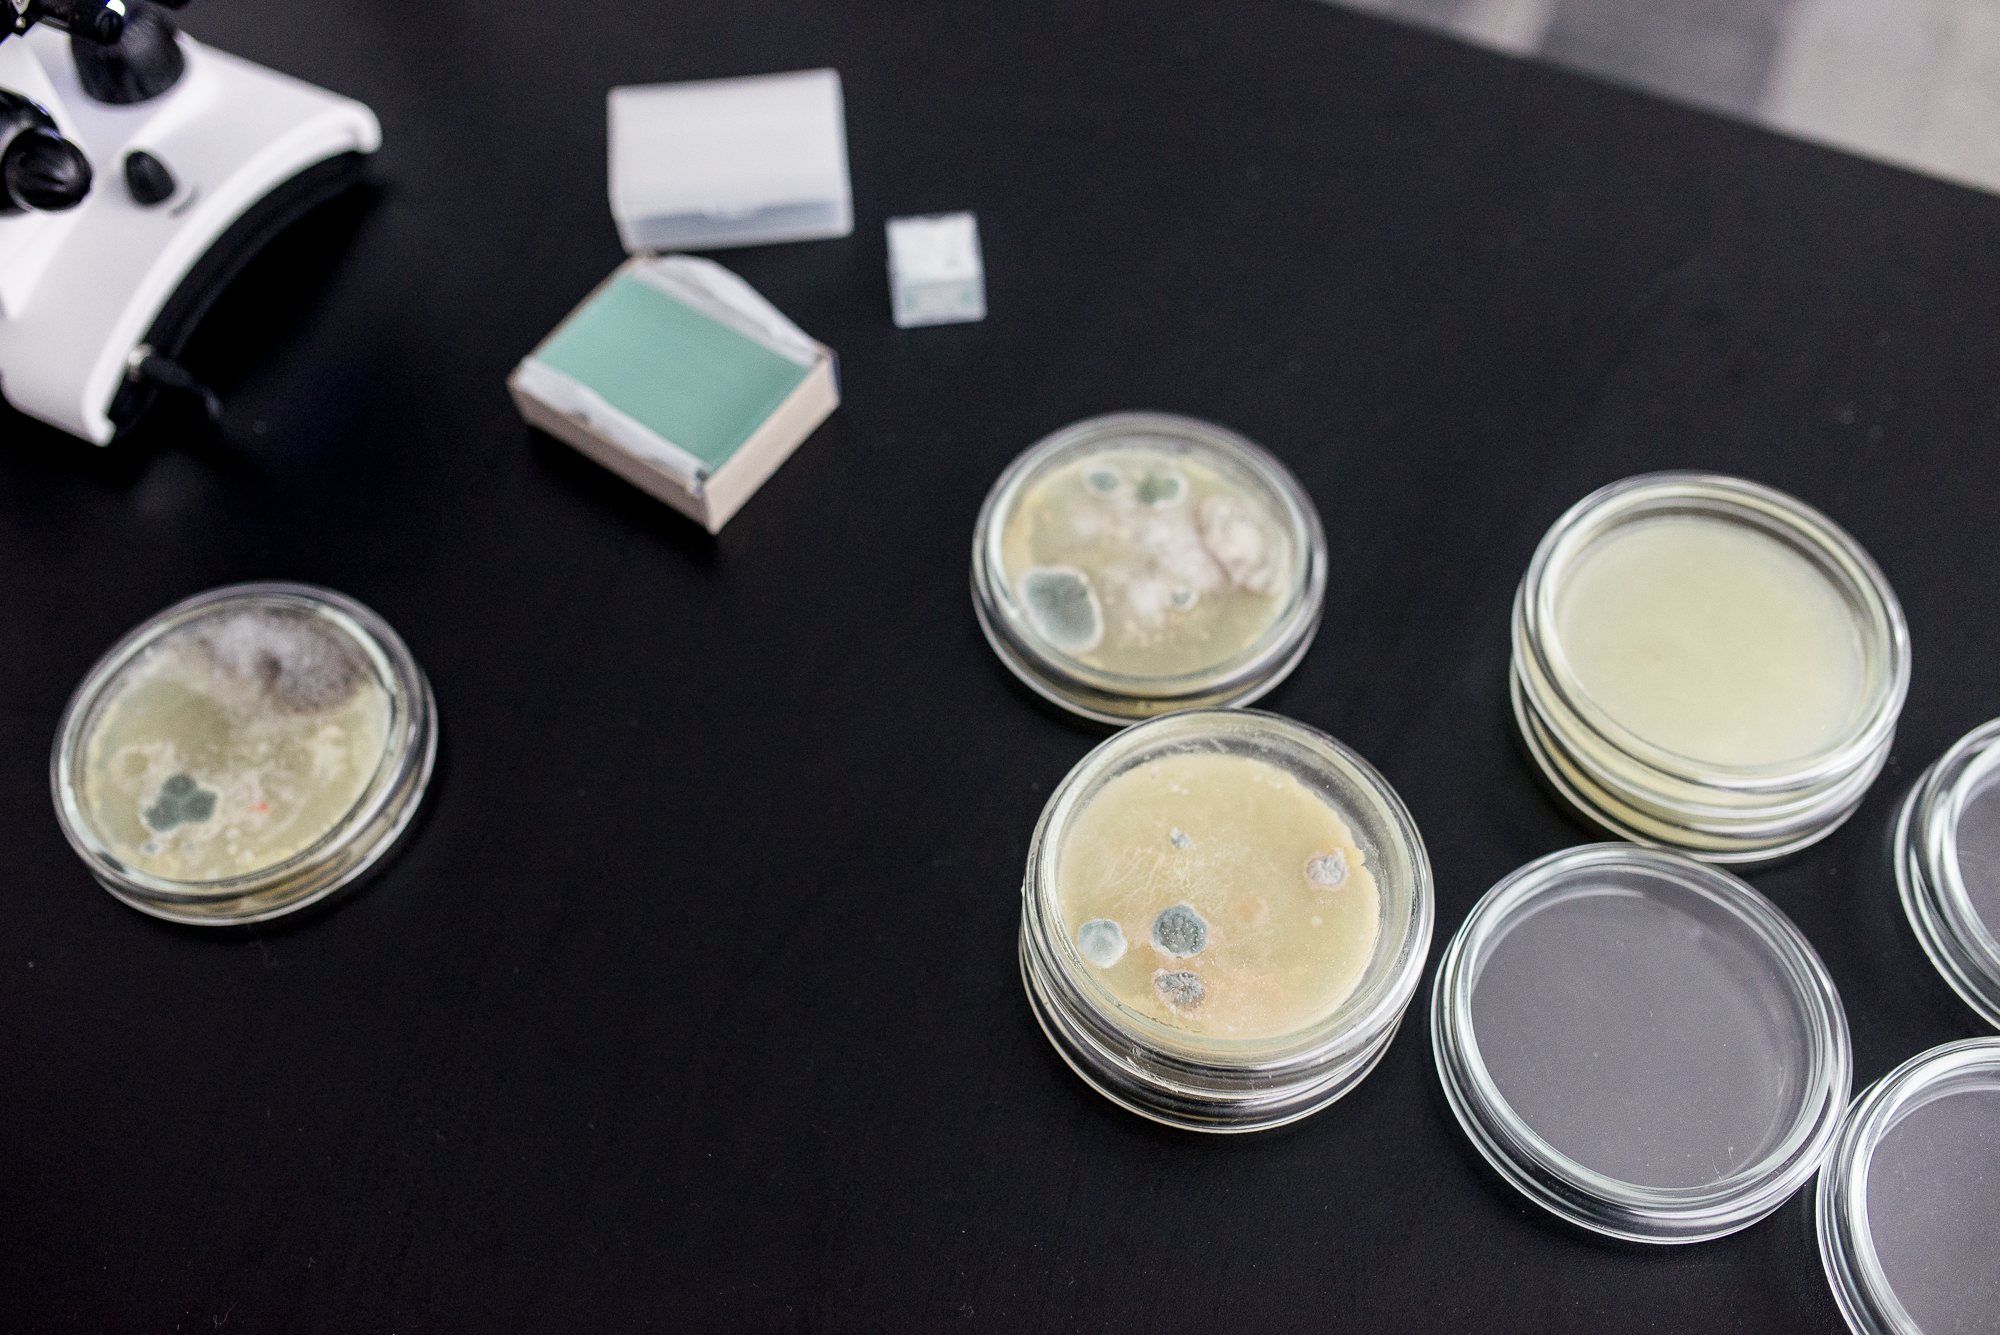

В PinchukArtCentre открылась выставка номинантов Премии арт-центра: под одной крышей кураторы собирают — вот уже в 5-й раз! — работы молодых художников со всей Украины. В этот раз экспозиция не выстраивалась вокруг одной темы: каждый художник высказывался о тех вещах и явлениях, которые сам считал важными. Одни обратились с общественно-политическими нарративами Украины, где происходит вооруженный конфликт, и исследовали его влияние на граждан. Вторые переосмысливают свои собственные, уже реализованные проекты, цитируя отдельные их элементы и внедряя их в новый контекст. Третьи уверенно смотрят в будущее, показывая проекты, построенные вокруг ряда утопий.
«Пятым конкурсом мы отмечаем 10 лет Премии PinchukArtCentre, главная задача которой — оказывать поддержку и создавать возможности для нового поколения украинских художников. После многих лет и большого количества художников, с которыми мы работали, я могу только с гордостью наблюдать появление радикально нового поколения, выходящего на арт-сцену. Их переживания, язык, темы — разные. Они показывают новый образ мышления и по-новому демонстрируют, каким может быть украинское искусство в будущем», — комментирует открытие Бйорн Гельдхоф, арт-директор PinchukArtCentre.
На Премию подавали заявки более 650 художников, и всего 20 из них попали в шорт-лист. Так, в здание арт-центра художник Михаил Алексеенко, который выставлялся на Фестивале молодых украинских художников в Арсенале, частично перенес свой проект — квартиру № 14 на Троещине — в зал арт-центра и поставил рядом автомат для сбора средств на реконструкцию троещинских памятников деконструктивизма. Анна Звягинцева, которая совсем недавно провела персональную выставку в том же PinchukArtCentre, собрала в одном пространстве композицию из 4-х разных объектов, продолжая исследовать тему едва уловимых мгновений жизни, а Дмитрий Старусев развесил по стенам гигантские «альтернативные фотографии» — бумажные негативы с химическим проявлением.

Саша Курмаз, который в октябре устроил публичный перформанс, главной задачей которого было не разнести старую машину вдребезги (как всем могло показаться), а обратить внимание на правильность парковки в городе, в «Пинчуке» разгромил целый зал. Он отказался давать комментарии и добавил, что внимательный зритель сможет сам понять его работу. Алина Клейтман «развесила» по нескольким залам искусственные шубы и мех и направила на них жуткие проекции, сопровождая их прерывистыми звуками (сморкания, например) — таким образом она обращается к детским страхам, которые живут в подсознании каждого зрителя. Еще на выставке можно увидеть проекты Юлианы Голуб, Екатерины Ермолаевой, Тараса Каменного, Николая Карабиновича, Виталия Кохана, Юлии Кривич, Лариона Лозового, Романа Михайлова, Олега Перковского, Сергея Радкевича, Евгения Самборского, Ивана Светличного, Павла Хайло, а также групп — Яремы Малащука и Романа Химея, Ревковского и Рачинского (Даниил Ревковский, Андрей Рачинский). Куратором выставки 20-ти номинантов на получение Премии PinchukArtCentre 2018 выступила Татьяна Кочубинская, которая также курирует исследовательскую платформу PinchukArtCentre.
Ко всему прочему, половину второго этажа арт-центра заняла персональная выставка художницы из ЮАР Динео Сеше Бопапе, которая стала обладательницей главной премии 4-го международного конкурса Future Generation Art Prize 2017. Она представила масштабную инсталляцию из земли, которой плотно покрыты пол и стены, и серии рисунков, созданных специально для PinchukArtCentre. Новое монументальное произведение, сделанное из украинской земли, напоминает в некотором смысле древние духовные места, а также проводит параллели с традиционной иконографией плодородности. В работе земля находится в состоянии постоянной трансформации: человек внедряет архитектурные объекты в природный топографический ландшафт, вызывая потерю водных ресурсов и наконец превращая землю в неплодородное полотно. Дополнить эту идею Бопапе помогает игра с травами, кристаллами, глиной, золотой фольгой и специально собранными образцами земли, происходящими из дюжины духовных мест по всему миру.
Украинская земля принимает в себя синергию знаков, верований, энергий и материалов, для которых в нашем языке не хватает слов. Земля твердая. Она создает фундамент и чувство принадлежности. Через образ земли художница обращается и к политической теме. Она определяет смысл государственности и идентичности, и в то же время она сохраняет внешнее спокойствие и нейтралитет. В работе же Бопапе земля превращается в реку. Она простирается от политики к духовной сфере (или от духовности к политике), возвращаясь и заново открывая утраченные традиции и глобальные маргинализированные системы верований. Едва заметным, но довольно важным моментом является запах немного сырой земли — он формирует атмосферу в пространстве экспозиции.